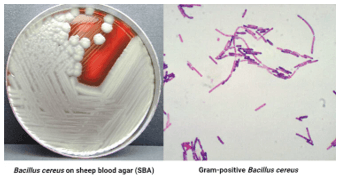
Giáo án Chuyên đề Sinh học 11 Kết nối tri thức Bài 10: Ngộ độc thực phẩm

Giáo án Chuyên đề Sinh học 11 Kết nối tri thức Bài 10: Ngộ độc thực phẩm
Giáo án Chuyên đề Sinh học 11 Kết nối tri thức Bài 10: Ngộ độc thực phẩm
Chỉ từ 200k mua trọn bộ Kế hoạch bài dạy (KHBD) hay Giáo án Chuyên đề Sinh 11 Kết nối tri thức chuẩn kiến thức, trình bày đẹp mắt, dễ dàng chỉnh sửa:
- B1: gửi phí vào tk:
1133836868- CT TNHH DAU TU VA DV GD VIETJACK - Ngân hàng MB (QR) - B2: Nhắn tin tới Zalo VietJack Official - nhấn vào đây để thông báo và nhận giáo án
I. MỤC TIÊU
1. Kiến thức
Sau bài học này, HS sẽ:
- Phân tích được một số nguyên nhân gây ngộ độc thực phẩm. Lấy được ví dụ minh họa.
- Phân tích được một số biện pháp phòng ngộ độc thực phẩm. Lấy được ví dụ minh họa.
2. Năng lực
Năng lực chung
- Năng lực tự chủ và tự học: thông qua các hoạt động tự đọc sách, tóm tắt được nội dung về ngộ độc thực phẩm, tự trả lời các câu hỏi ở mục Dừng lại và suy ngẫm.
- Năng lực hợp tác và giao tiếp: thông qua trao đổi ý kiến, phân công công việc trong thảo luận nhóm về các nội dung ngộ độc thực phẩm.
- Năng lực sử dụng ngôn ngữ: thông qua trình bày kết quả thảo luận trong nhóm và trước lớp về các nội dung ngộ độc thực phẩm.
- Năng lực giải quyết vấn đề và sáng tạo: vận dụng những kiến thức về ngộ độc thực phẩm để biết cách phòng, chống và nhận biết sớm tình trạng ngộ độc thực phẩm và có biện pháp xử lí kịp thời.
Năng lực sinh học
- Vận dụng kiến thức, kĩ năng đã học: Vận dụng kiến thức, kĩ năng đã học về ngộ độc thực phẩm để áp dụng vào thực tiễn đời sống, đề xuất một số giải pháp phòng ngộ độc thực phẩm trong gia đình.
3. Phẩm chất
- Chăm chỉ: tích cực, chủ động học tập, hứng thú tìm hiểu những nội dung liên quan đến ngộ độc thực phẩm.
- Trung thực và trách nhiệm: thực hiện đúng các nhiệm vụ được phân công (trong thảo luận nhóm, điều tra), có ý thức báo cáo đúng kết quả đã làm.
II. THIẾT BỊ DẠY HỌC
1. Đối với giáo viên
- SCĐ, SGV chuyên đề học tập Sinh học 11 kết nối tri thức.
- Máy tính, máy chiếu (nếu có).
- Tranh ảnh hoặc tập tin (file), video,... về các tác nhân gây ngộ độc thực phẩm và một số thực phẩm có nguy cơ cao gây ngộ độc.
2. Đối với học sinh
- SCĐ chuyên đề học tập Sinh học 11 kết nối tri thức.
- Vở ghi, dụng cụ học tập.
III. TIẾN TRÌNH DẠY HỌC
A. HOẠT ĐỘNG KHỞI ĐỘNG (MỞ ĐẦU)
a) Mục tiêu: Kiểm tra kiến thức, tạo hứng thú cho HS dễ dàng tiếp thu bài học mới.
b) Nội dung: GV chiếu video về ngộ độc thực phẩm ở Việt Nam, đặt vấn đề; HS vận dụng hiểu biết trả lời câu hỏi Khởi động SCĐ trang 45.
c) Sản phẩm: Câu trả lời của HS cho câu hỏi Khởi động SCĐ trang 45.
d) Tổ chức thực hiện:
Bước 1: Chuyển giao nhiệm vụ:
- GV đặt vấn đề: Hằng năm, có hàng trăm vụ ngộ độc thực phẩm xảy ra trên toàn quốc, gây nên những thiệt hại nghiêm trọng về sức khỏe, tính mạng, kinh tế của người dân.
- GV chiếu video phóng sự về tình trạng ngộ độc thực phẩm đã được ghi nhận trong thời gian gần đây tại Việt Nam: https://youtu.be/Vss0poDpoWY?si=-TXPFwTcVVPM9ysK
- GV yêu cầu HS quan sát các hình ảnh trên và trả lời câu hỏi Khởi động tr.45 SCĐ: Vậy theo em, ngộ độc thực phẩm là gì? Nguyên nhân nào gây nên ngộ độc thực phẩm? Làm cách nào có thể phát hiện và phòng ngừa ngộ độc thực phẩm?
Bước 2: Thực hiện nhiệm vụ:
- HS quan sát video, vận dụng hiểu biết của bản thân để trả lời câu hỏi Khởi động tr.45 SCĐ.
- GV quan sát, hướng dẫn (nếu cần).
Bước 3: Báo cáo thảo luận:
- GV mời 1 - 2 HS trả lời theo ý kiến cá nhân.
- HS khác nhận xét, bổ sung.
Bước 4: Kết luận và nhận xét:
- GV ghi nhận các câu trả lời của HS.
- GV nhận xét, đánh giá và dẫn dắt vào bài học mới: - Bài 10: Ngộ độc thực phẩm.
B. HÌNH THÀNH KIẾN THỨC MỚI
Hoạt động 1: Tìm hiểu về định nghĩa và nguyên nhân gây ngộ độc thực phẩm
a) Mục tiêu: HS phân tích được một số nguyên nhân gây ngộ độc thực phẩm và lấy được ví dụ minh họa.
b) Nội dung: GV trình bày vấn đề; HS đọc hiểu SCĐ trang 45 - 51, quan sát Hình 10.1 - 10.10, thực hiện nhiệm vụ.
c) Sản phẩm: Định nghĩa và nguyên nhân gây ô nhiễm thực phẩm.
d) Tổ chức thực hiện:
HĐ CỦA GV VÀ HS |
SẢN PHẨM DỰ KIẾN |
|
Bước 1: Chuyển giao nhiệm vụ - GV yêu cầu HS trả lời câu hỏi khái niệm ngộ độc thực phẩm. - GV chia lớp thành 8 nhóm. - GV yêu cầu các nhóm HS đọc hiểu mục II tr.45 - 52 SCĐ, thực hiện nhiệm vụ sau: Nhóm 1, 2: Đọc hiểu mục II.1, quan sát Hình 10.1 - 10.4, trình bày nguyên nhân ngộ độc thực phẩm do nhiễm vi sinh vật. Nhóm 3, 4: Đọc hiểu mục II.2, quan sát Hình 10.5 - 10.8, trình bày nguyên nhân ngộ độc thực phẩm do các chất hóa học. Nhóm 5,6: Đọc hiểu mục II.3, quan sát Hình 10.9, trình bày nguyên nhân ngộ độc thực phẩm do chất độc tự nhiên có sẵn trong thực phẩm. Nhóm 7, 8: Đọc hiểu mục II.4, quan sát Hình 10.10, trình bày nguyên nhân ngộ độc thực phẩm do thực phẩm bị hư hỏng, biến chất. - GV yêu cầu về cách trình bày của các nhóm: + Nhóm 1, 3, 5, 7: trình bày nội dung bằng cách tạo bảng. + Nhóm 2, 4, 6, 8: trình bày nội dung bằng sơ đồ tư duy. - GV yêu cầu mỗi nhóm cử ra 1 nhóm trưởng và 1 thư kí: + Trưởng nhóm phân công nhiệm vụ cho từng thành viên; + Thư kí ghi chép ý kiến của các thành viên và tổng hợp kết quả báo cáo của cả nhóm sau khi đã thống nhất. |
I. Định nghĩa - Ngộ độc thực phẩm là tình trạng bệnh do hấp thụ thực phẩm bị ô nhiễm hoặc có chứa chất độc. II. Nguyên nhân gây ngộ độc thực phẩm 1. Ngộ độc thực phẩm do nhiễm vi sinh vật a) Tác nhân gây ngộ độc - Vi khuẩn như Salmonella, Campylobacter, Escherichia coli, Clostridium botulinum, Staphylococcus aureus,... có trong thực phẩm có thể gây bệnh nhiễm khuẩn, ngộ độc cho người ăn. Staphylococcus aureus (tụ cầu vàng) - Virus: có thể gây ngộ độc cho người thông qua việc ăn, uống thực phẩm bị nhiễm virus hoặc dùng chung bát, đũa, thìa, cốc,... với người bệnh. Những virus này được chia thành các nhóm dựa trên các triệu chứng bệnh lí: + Nhóm gây ra bệnh viêm dạ dày ruột (ví dụ: Norwalkvirus). + Nhóm virus gây viêm gan (ví dụ: virus viêm gan A sinh trưởng trong gan). |
................................
................................
................................
Trên đây tóm tắt một số nội dung miễn phí trong bộ Kế hoạch bài dạy (KHBD) hay Giáo án Chuyên đề Sinh học 11 mới nhất, để mua tài liệu đầy đủ, Thầy/Cô vui lòng xem thử:
Xem thêm các bài soạn Giáo án Chuyên đề Sinh học lớp 11 Kết nối tri thức hay, chuẩn khác:
Giáo án Chuyên đề Sinh học 11 Bài 6: Nguyên nhân lây nhiễm bệnh dịch ở người
Giáo án Chuyên đề Sinh học 11 Bài 7: Các biện pháp phòng, chống bệnh dịch ở người
Giáo án Chuyên đề Sinh học 11 Bài 9: Khái quát về vệ sinh an toàn thực phẩm
Đã có app VietJack trên điện thoại, giải bài tập SGK, SBT Soạn văn, Văn mẫu, Thi online, Bài giảng....miễn phí. Tải ngay ứng dụng trên Android và iOS.
Theo dõi chúng tôi miễn phí trên mạng xã hội facebook và youtube:Nếu thấy hay, hãy động viên và chia sẻ nhé! Các bình luận không phù hợp với nội quy bình luận trang web sẽ bị cấm bình luận vĩnh viễn.
- Giáo án lớp 11 (các môn học)
- Giáo án điện tử lớp 11 (các môn học)
- Giáo án Toán 11
- Giáo án Ngữ văn 11
- Giáo án Tiếng Anh 11
- Giáo án Vật Lí 11
- Giáo án Hóa học 11
- Giáo án Sinh học 11
- Giáo án Lịch Sử 11
- Giáo án Địa Lí 11
- Giáo án KTPL 11
- Giáo án HĐTN 11
- Giáo án Tin học 11
- Giáo án Công nghệ 11
- Giáo án GDQP 11
- Đề thi lớp 11 (các môn học)
- Đề thi Ngữ Văn 11 (có đáp án)
- Chuyên đề Tiếng Việt lớp 11
- Đề cương ôn tập Văn 11
- Đề thi Toán 11 (có đáp án)
- Đề thi Toán 11 cấu trúc mới
- Đề cương ôn tập Toán 11
- Đề thi Tiếng Anh 11 (có đáp án)
- Đề thi Tiếng Anh 11 mới (có đáp án)
- Đề thi Vật Lí 11 (có đáp án)
- Đề thi Hóa học 11 (có đáp án)
- Đề thi Sinh học 11 (có đáp án)
- Đề thi Lịch Sử 11
- Đề thi Địa Lí 11 (có đáp án)
- Đề thi KTPL 11
- Đề thi Tin học 11 (có đáp án)
- Đề thi Công nghệ 11
- Đề thi GDQP 11 (có đáp án)

Giải bài tập SGK & SBT
Giải bài tập SGK & SBT
 Tài liệu giáo viên
Tài liệu giáo viên
 Sách
Sách
 Khóa học
Khóa học
 Thi online
Thi online
 Hỏi đáp
Hỏi đáp

